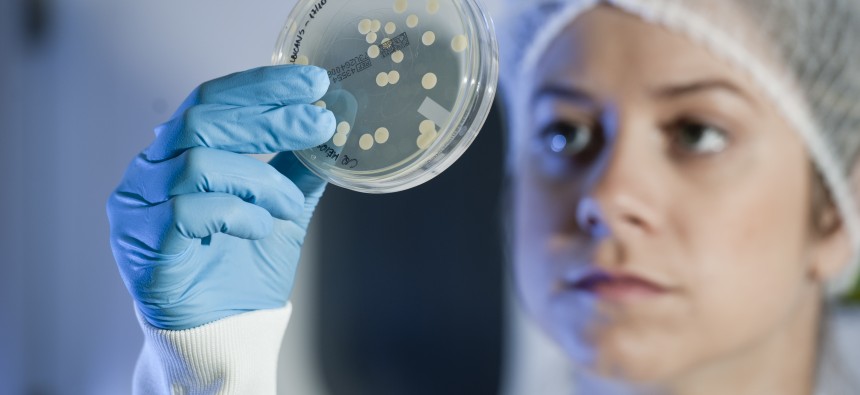

Relatório Social do Brasil Marista 2021

Na educação habita a esperança – Versão Web
Relatório Social do Brasil Marista 2020

Ressignificar novos tempos pedem novos olhares – Versão Web.
Relatório Social 2019: Brasil Marista em dados

A União Marista do Brasil (UMBRASIL) lança o Relatório Social do Brasil Marista 2019, que contêm dados gerenciais das áreas de atuação marista: Direitos Humanos, Educação Básica, Educação Superior, Saúde, Solidariedade, Evangelização, Responsabilidade Socioambiental, Editorial, Voluntariado, Riscos e Compliance, Representação Institucional e Patrimônio e Espiritual Marista. O anuário, que segue as diretrizes da Global […]
Relatório Social 2018

Acesse aqui!
Relatório Social do Brasil Marista 2017

Versão digital
Relatório Social 2016

VERSÃO DIGITAL VERSÃO PDF
Relatório Social 2016

👉 Acessar versão PDF 👉 Acessar versão digital
Relatório Social 2015

👉 Acessar versão PDF 👉 Acessar versão digital
Relatório Social- Brasil Marista em dados

No dia 31 de outubro, a UMBRASIL fará o lançamento, em formato digital, do Relatório Social 2016. Coordenado pela UMBRASIL, o Relatório contribui para registrar as ações desenvolvidas pelas Unidades das Províncias do Brasil Marista. No documento são apresentados conteúdos que destacam os dados gerenciais, as áreas de atuação Marista (direitos humanos, educação, saúde, comunicação, […]
Saúde no Brasil Marista
Pautada pela Missão de São Marcelino Champagnat e fundamentados em princípios éticos, cristãos e maristas, a área de Saúde Marista está em constate busca da construção de novos conhecimentos. O Instituto do Cérebro do Rio Grande do Sul – PUCRS (InsCer), faz parte da área de saúde do Brasil Marista. Um dos principais objetivos […]
